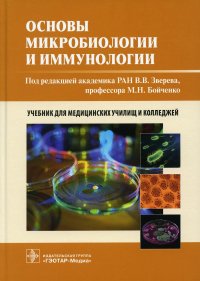

18+
На сайте представлено только описание и выходные данные книги «Основы микробиологии и иммунологии: Учебник М. Н. Бойченко, В. В. Зверев, А. С. Быков». Сайт не является распространителем книги. Сайт не предоставляет возможности купить, читать онлайн или скачать бесплатно книгу «Основы микробиологии и иммунологии: Учебник М. Н. Бойченко, В. В. Зверев, А. С. Быков». Сайт предназначен для лиц старше 18 лет. Если вам не исполнилось 18 лет - незамедлительно покиньте сайт. Оставаясь на сайте вы подтверждаете, что вам исполнилось 18 лет.
Незаконное потребление наркотических средств, психотропных веществ, их аналогов причиняет вред здоровью, их незаконный оборот запрещен и влечет установленную законодательством ответственность
Учебник соответствует программе, разработанной ГАПОУ «Казанский медицинский колледж» на основе федерального государственного образовательного стандарта среднего профессионального образования по специальностям 31.02.01 «Лечебное дело», 32.02.02 «Акушерское дело», 34.02.01 «Сестринское дело». Книга включает 15 глав, в которых рассмотрены вопросы общей и частной микробиологии, вирусологии и иммунологии. Особое внимание уделено вопросам забора и доставки в лабораторию исследуемого материала, уничтожения биологических отходов. Теоретический материал проиллюстрирован таблицами и рисунками. К каждой главе даны вопросы для самоконтроля. Издание предназначено студентам медицинских училищ и колледжей. Это и многое другое вы найдете в книге Основы микробиологии и иммунологии: Учебник (А. С. Быков, М. Н. Бойченко, В. В. Зверев)
| Полное название книги | М. Н. Бойченко, В. В. Зверев, А. С. Быков Основы микробиологии и иммунологии: Учебник |
| Тип | Книга |
| Авторы | М. Н. Бойченко, В. В. Зверев, А. С. Быков |
| Категории | Книги, Медицина и здоровье. ЗОЖ |
| ISBN | 9785970461990 |
| Возрастное ограничение | 18 |
| Издательство | ГЭОТАР-Медиа |
| Год | 2021 |
| Название транслитом | osnovy-mikrobiologii-i-immunologii-uchebnik-a-s-bykov-m-n-boychenko-v-v-zverev |
| Просмотров | 8 |
| Рейтинг izbe.ru | 0,0 |

Мари Мур

Брук Лин

Конкордия Антарова

Дэниел Киз

Абрахам Вергезе

Аида Синицына

Вадим Зеланд

Сергей Лукьяненко

Роберт Грин

Виктор Дашкевич

Роман Прокофьев

Пауло Коэльо